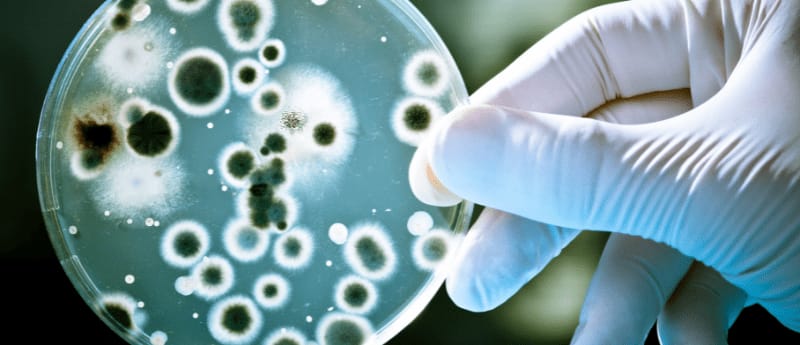

Cep telefonlarının araştırmalar sonucunda en kirli nesnelerden biri olduğu ortaya çıktı. Birçok yüzeyden daha fazla bakteri taşıyorlar ve muhtemelen tuvalet oturağınızdan daha da kirliler, özellikle de tuvalet oturağınızı telefonunuzdan daha sık temizliyorsanız..
Cep telefonlarımıza çok fazla bağlıyız, tuvalete giderken bile kullananlar, video izleyenler ayakları uyuşanlar ne demek istediğimi anlamıştır. Neredeyse her alanda bizimle beraberler; yemek masasında, yatakta, otururken, işe giderken, araba kullanırken..
Bunlar yetmez gibi birde çoğumuz telefonları tuvalate de götürmeye başladı.
Cep telefonları, bazılarının " özel işlerini" yaparken vakit geçirmek için kullandıkları gazete veya dergilerin yerini almış durumda. Aslına tuvaletteyken gazete okuma kültürü normalde bizim kültürümüze ters bir hareketken şimdi telefonları kullanır olduk.
Kalbimize yüzümüze bu kadar yakın tuttuğumuz bu cep telefonlarına gerekli temizliği sağlamıyorsanız size üzücü bir haber vermem gerekecek.
Cep telefonlarınızın tuvalet oturaklarından daha kirli olduklarını söylesem ne düşünürsünüz?

Telefonlarımızda Yaşayan Binlerce Bakteri..
İnsan vücudunda trilyonlarca bakteri hücreleri bulunur. Vücudumuzda bulunan her hücre için 10 bakteri vardır. Etrafımızdaki bakterilerin, vücudumuzda bulunan bakterilerin ezici varlığını düşündüğümüzde, telefon ekranlarımızda da bulunmaları çok da şaşırtıcı olmamalı.
En son yapılan bir araştırmada, erkek ve kız lise öğrencilerine ait 17 örnek telefonda 17.000'den fazla bakteri geninin kopyası bulundu.
Maalesef bu durum, telefonları her gün kullandığımız en kirli ve iğrenç şeylerden biri haline getiriyor.
Peki, cildimizde de zaten bakteriler yaşıyorsa, telefonlardaki bakteriler neden bu kadar önemli oluyor?
Tıpkı bağırsaklarımızda olduğu gibi, belirli bakteri grupları cildimizde bulunurlar ve barış içinde yaşar. Bu tür "iyi" bakterilerden biri
Staphylococcus epidermidis'tir.
Bir çalışma, bu bakterinin cildin sağlıklı bir dış tabakasını korumaya yardımcı olan bir enzim (sfingomiyelinaz) ürettiğini buldu. Yani bize fayda sağlayan bir bakteri ancak her bakteri bu kadar masum değil elbette.

Tam tersine, Propionibacterium acnes gibi bakteriler çoğumuzun sahip olduğu o ağrılı ve çirkin sivilcelerin arkasındaki suçludur.
Günümüzde, telefonlarımızın ellerimize yapıştığını düşünürsek, bu tür bakterilerin telefonumuzdan cildimize kolayca sıçraması oldukça basit görünüyor. Peki Telefonlarımızdaki Bakteriler ne kadar tehlikeli?
Telefonlar Tuvalet Oturaklarımızdan Daha mı Kirli?
Telefonlarımızda yer alan bakterilerle ilgili bir araştırma yapılmış bununla ilgili 56 makale incelenmiş ve telefonlarda en sık karşılaşan birkaç bakteri türü tespit edilmiş.
E.coli, Salmonella, Staphylococcus aureus, Coagulase Negative Staphylococci (CoNS) ve Pseudomonas türlerinde bakteriler.
Bunlar fırsatçı patojenler olarak kabul edilir, yani normal koşullar altında zayıf bağışıklığı olan kişiler dışında herhangi bir tehdit oluşturmazlar.
Escherichia coli (E.coli), fekal koliform bakteri olarak da bilinir, cep telefonlarında bulunan en baskın bakterilerden biridir.
Adına bakarak dışkıyla ilgili olduğunu tahmin etmek zor değil. E.coli, insanların ve hayvanların bağırsaklarında ve taze dışkıda bulunur.
Telefonunuzu bir dahaki sefere tuvalete götürdüğünüzde bunu düşünün. E. coli'nin telefonunuzda bulunması, telefonunuzda bir miktar dışkının da bulunma olasılığının yüksek olduğu anlamına gelir.

Staphylococcus aureus kültürlerin yaklaşık %12,8'inde telefonlarımızda mevcut. Çoğu durumda zararsızdır, ancak eğer ki vücudunuza girerse hafif cilt enfeksiyonundan zatürreye kadar değişen sağlık sorunlarına neden olabilecek bir bakteridir.
Staphylococcus saprophyticus ve Staphylococcus epidermidis doğal olarak ciltte ve cildin mukoza zarlarında bulunur. Doğru sıcaklık, nem miktarı ve telefon yüzeyinin yetersiz temizlenmesi gibi durumlarda, uygun koşullar altında patojen hale gelerek hastalıklara neden olurlar.
Bakterilerileri atlattıysak sıra mantarlarda. Bakterilerin yanı sıra mantarlar da cep telefonlarının ara sıra kirleticileri olarak hareket eder.
Mantarlar cilt döküntülerine neden olabilirken, küf solunum sistemine saldırarak solunum sıkıntısına bile neden olma ihtimaline sahiptir.
Cep telefonlarında çok sayıda bakteri bulunduğu gerçeğini kabul etsek bile, gerçekten bir tuvaletten daha kirli olabilirler mi?
Birçok popüler bilim dergilerine göre, evet olabilir.
Dr. Charles Gerba bunu Arizona Üniversitesi blogu ve USA Today için doğruladı. Cep telefonlarının bir tuvalet koltuğundan 10 kat daha kirli olduğu istatistiğini insanlara kanıtladı.
Başka popüler kaynaklara göre telefonlar en kirli nesneler arasında birinci sırada yer almayı başardı.
Bu iddia, etrafımızdaki masalar ve sandalyeler gibi çeşitli diğer yüzeylerle karşılaştırıldığında, araştırmalar bunu doğruluyor.
Cep telefonlarının tuvaletle kıyaslanmasının sebebi, tuvaletleri pis alanlar gördüğümüz için sık sık temizlerken, telefonlarımız oldukça temiz göründüğünden, ekranda görüntüyü göstermeyecek kadar kirlenmedikçe temizleme gereği çoğu insan duymuyor.
Hatta daha da kötüsü tuvalete telefonlarla giriliyor. Bu da bakterilerin oradan oraya gezme olasılığını oldukça arttırıyor.

Cep Telefonlarından Daha Kirli Bir Şey Var Mı?
Telefonların ne kadar kirli olduğunu öğrendiğimize göre, bu çirkin yarışta telefonları yenebilecek bir şey var mı diye de düşünmüş olabilirsiniz. Evet telefonların bir rakibi var neredeyse aynı oranda kirlilik sunan; Paralar..
Belli değeri olan ve çok kez elden ele dolaşan kağıt veya metal parçası. Bunların elimize ulaşma serüvenine baktığımız zaman bile midemiz bulanabiliyor.
Birinin diğerinden "daha kirli" olduğunu söylemek tam anlamıyla doğru olmaz. Para da telefonlarla karşılaştırıldığında mikroplar tarafından eşit derecede (hatta daha fazla) kirletilen nesneler.
New York City'deki araştırmacılar bu teoriyi doğrulamak için 1 dolarlık banknotlar sildiler ve incelediler.
Bilim insanları bu paralarda oldukça belirgin insan DNA'sı bulmanın yanı sıra, yaban domuzu ve gri kurt gibi evcil hayvanların ve vahşi hayvanların DNA'sını bile buldular.
Ayrıca farklı mantar türlerine de rastladılar.
Staphylococcus epidermis gibi yaygın cilt bakterileri ve Streptococcus oralis gibi oral bakteriler de vardı bu paralarda yer alıyordu.
Başka bir çalışma, madeni paralarda Staphylococcus aureus, Salmonella türleri ve Escherichia coli'nin varlığını ortaya çıkardı.
Daha ilginç bir şey söyleyeyim; İngiltere banknotlarında eroin, kokain THC ve MDMA izleri bulundu. ABD' de benzer bir manzara var. Dolar banknotlarının %92'sinde morfin, eroin, metamfetamin ve amfetaminin yanı sıra kokain izleri de vardı.

Herhangi bir hastalığın başkalarına ve kendimize yayılmasını istemiyorsak ki kimse istemez, hastane gibi alanlara özellikle gidildiğinde telefonu dezenfekte etmeye önem göstermeliyiz.
Dışardan eve gelindiğinde toplu taşımalar ya da başka yerlere temas edildiğinden dolayı nasıl ellerimizi yıkıyorsak aynı şekilde bizimle dışarda olan ve elimizden hiçbir ortamda düşürmediğimiz telefonlarımızı da temizlememiz önemlidir.
Tabi ne kadar uğraşırsak uğraşalım bakteriler etrafımızda her zaman. Dünyadaki tüm dezenfektanlara rağmen, bakteriler telefonunuza ulaşmanın yolunu bir şekilde bulacaktır.
Bakteriler telefonda huzur içinde yaşarlar çünkü temizlemek zor bir iştir, bu yüzden nadiren temizlenirler. Ayrıca, telefonun sıcak yüzeyi onu bakterilerin büyümesi için rahat bir yer haline getirir.
Bakterileri yok edemesek de en aza indirmek için yapabileceğiniz şey "tuvalette mesaj göndermekten ya da video izlemekten" kaçınmak olacaktır.
Aynı zamanda bir şeyler yerken ınstagramda gezinmeden önce iki kere düşünmek gerekir.
Cep telefonlarımızdan belirli süreler uzak kalmak hem ruhsal hem bedensel sağlığımız için önemlidir.

Staphylococcus aureus kültürlerin yaklaşık %12,8'inde telefonlarımızda mevcut. Çoğu durumda zararsızdır, ancak eğer ki vücudunuza girerse hafif cilt enfeksiyonundan zatürreye kadar değişen sağlık sorunlarına neden olabilecek bir bakteridir.
Staphylococcus saprophyticus ve Staphylococcus epidermidis doğal olarak ciltte ve cildin mukoza zarlarında bulunur. Doğru sıcaklık, nem miktarı ve telefon yüzeyinin yetersiz temizlenmesi gibi durumlarda, uygun koşullar altında patojen hale gelerek hastalıklara neden olurlar.
Bakterilerileri atlattıysak sıra mantarlarda. Bakterilerin yanı sıra mantarlar da cep telefonlarının ara sıra kirleticileri olarak hareket eder.
Mantarlar cilt döküntülerine neden olabilirken, küf solunum sistemine saldırarak solunum sıkıntısına bile neden olma ihtimaline sahiptir.
Cep telefonlarında çok sayıda bakteri bulunduğu gerçeğini kabul etsek bile, gerçekten bir tuvaletten daha kirli olabilirler mi?
Birçok popüler bilim dergilerine göre, evet olabilir.
Dr. Charles Gerba bunu Arizona Üniversitesi blogu ve USA Today için doğruladı. Cep telefonlarının bir tuvalet koltuğundan 10 kat daha kirli olduğu istatistiğini insanlara kanıtladı.
Staphylococcus aureus kültürlerin yaklaşık %12,8'inde telefonlarımızda mevcut. Çoğu durumda zararsızdır, ancak eğer ki vücudunuza girerse hafif cilt enfeksiyonundan zatürreye kadar değişen sağlık sorunlarına neden olabilecek bir bakteridir.
Staphylococcus saprophyticus ve Staphylococcus epidermidis doğal olarak ciltte ve cildin mukoza zarlarında bulunur. Doğru sıcaklık, nem miktarı ve telefon yüzeyinin yetersiz temizlenmesi gibi durumlarda, uygun koşullar altında patojen hale gelerek hastalıklara neden olurlar.
Bakterilerileri atlattıysak sıra mantarlarda. Bakterilerin yanı sıra mantarlar da cep telefonlarının ara sıra kirleticileri olarak hareket eder.
Mantarlar cilt döküntülerine neden olabilirken, küf solunum sistemine saldırarak solunum sıkıntısına bile neden olma ihtimaline sahiptir.
Cep telefonlarında çok sayıda bakteri bulunduğu gerçeğini kabul etsek bile, gerçekten bir tuvaletten daha kirli olabilirler mi?
Birçok popüler bilim dergilerine göre, evet olabilir.
Dr. Charles Gerba bunu Arizona Üniversitesi blogu ve USA Today için doğruladı. Cep telefonlarının bir tuvalet koltuğundan 10 kat daha kirli olduğu istatistiğini insanlara kanıtladı.

 Herhangi bir hastalığın başkalarına ve kendimize yayılmasını istemiyorsak ki kimse istemez, hastane gibi alanlara özellikle gidildiğinde telefonu dezenfekte etmeye önem göstermeliyiz.
Dışardan eve gelindiğinde toplu taşımalar ya da başka yerlere temas edildiğinden dolayı nasıl ellerimizi yıkıyorsak aynı şekilde bizimle dışarda olan ve elimizden hiçbir ortamda düşürmediğimiz telefonlarımızı da temizlememiz önemlidir.
Tabi ne kadar uğraşırsak uğraşalım bakteriler etrafımızda her zaman. Dünyadaki tüm dezenfektanlara rağmen, bakteriler telefonunuza ulaşmanın yolunu bir şekilde bulacaktır.
Bakteriler telefonda huzur içinde yaşarlar çünkü temizlemek zor bir iştir, bu yüzden nadiren temizlenirler. Ayrıca, telefonun sıcak yüzeyi onu bakterilerin büyümesi için rahat bir yer haline getirir.
Bakterileri yok edemesek de en aza indirmek için yapabileceğiniz şey "tuvalette mesaj göndermekten ya da video izlemekten" kaçınmak olacaktır.
Aynı zamanda bir şeyler yerken ınstagramda gezinmeden önce iki kere düşünmek gerekir.
Cep telefonlarımızdan belirli süreler uzak kalmak hem ruhsal hem bedensel sağlığımız için önemlidir.
Herhangi bir hastalığın başkalarına ve kendimize yayılmasını istemiyorsak ki kimse istemez, hastane gibi alanlara özellikle gidildiğinde telefonu dezenfekte etmeye önem göstermeliyiz.
Dışardan eve gelindiğinde toplu taşımalar ya da başka yerlere temas edildiğinden dolayı nasıl ellerimizi yıkıyorsak aynı şekilde bizimle dışarda olan ve elimizden hiçbir ortamda düşürmediğimiz telefonlarımızı da temizlememiz önemlidir.
Tabi ne kadar uğraşırsak uğraşalım bakteriler etrafımızda her zaman. Dünyadaki tüm dezenfektanlara rağmen, bakteriler telefonunuza ulaşmanın yolunu bir şekilde bulacaktır.
Bakteriler telefonda huzur içinde yaşarlar çünkü temizlemek zor bir iştir, bu yüzden nadiren temizlenirler. Ayrıca, telefonun sıcak yüzeyi onu bakterilerin büyümesi için rahat bir yer haline getirir.
Bakterileri yok edemesek de en aza indirmek için yapabileceğiniz şey "tuvalette mesaj göndermekten ya da video izlemekten" kaçınmak olacaktır.
Aynı zamanda bir şeyler yerken ınstagramda gezinmeden önce iki kere düşünmek gerekir.
Cep telefonlarımızdan belirli süreler uzak kalmak hem ruhsal hem bedensel sağlığımız için önemlidir.


